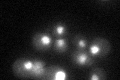
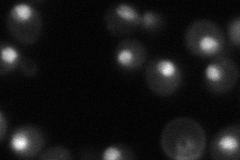

View description
Poly(A) polymerase, one of three factors required for mRNA 3'-end polyadenylation, forms multiprotein complex with polyadenylation factor I (PF I), also required for mRNA nuclear export; may also polyadenylate rRNAs
Localization:
Intensity:
Fold change:
Significance:
-
C’ GFP library in SD
nucleus38.86 -
N' NOP1pr-GFP in SD

nucleus92.2542 -
N' TEF2pr-mCherry in SD

nucleus69.3458 -
N' NATIVEpr-GFP in SD
nucleus57.8135 -
N' TEF2pr-VC and Cyto-VN in SD

#N/A0 -
C’ GFP library in SD+DTT

nucleus41.21.05No -
C’ GFP library in SD+H2O2

nucleus46.221.18No -
C’ GFP library in Starvation Media

nucleus45.851.17No -
C’ GFP library on the background of Pup2-DaMP

N/A -
C’ GFP library on the background of CCT mutant

N/A0N/AYes
